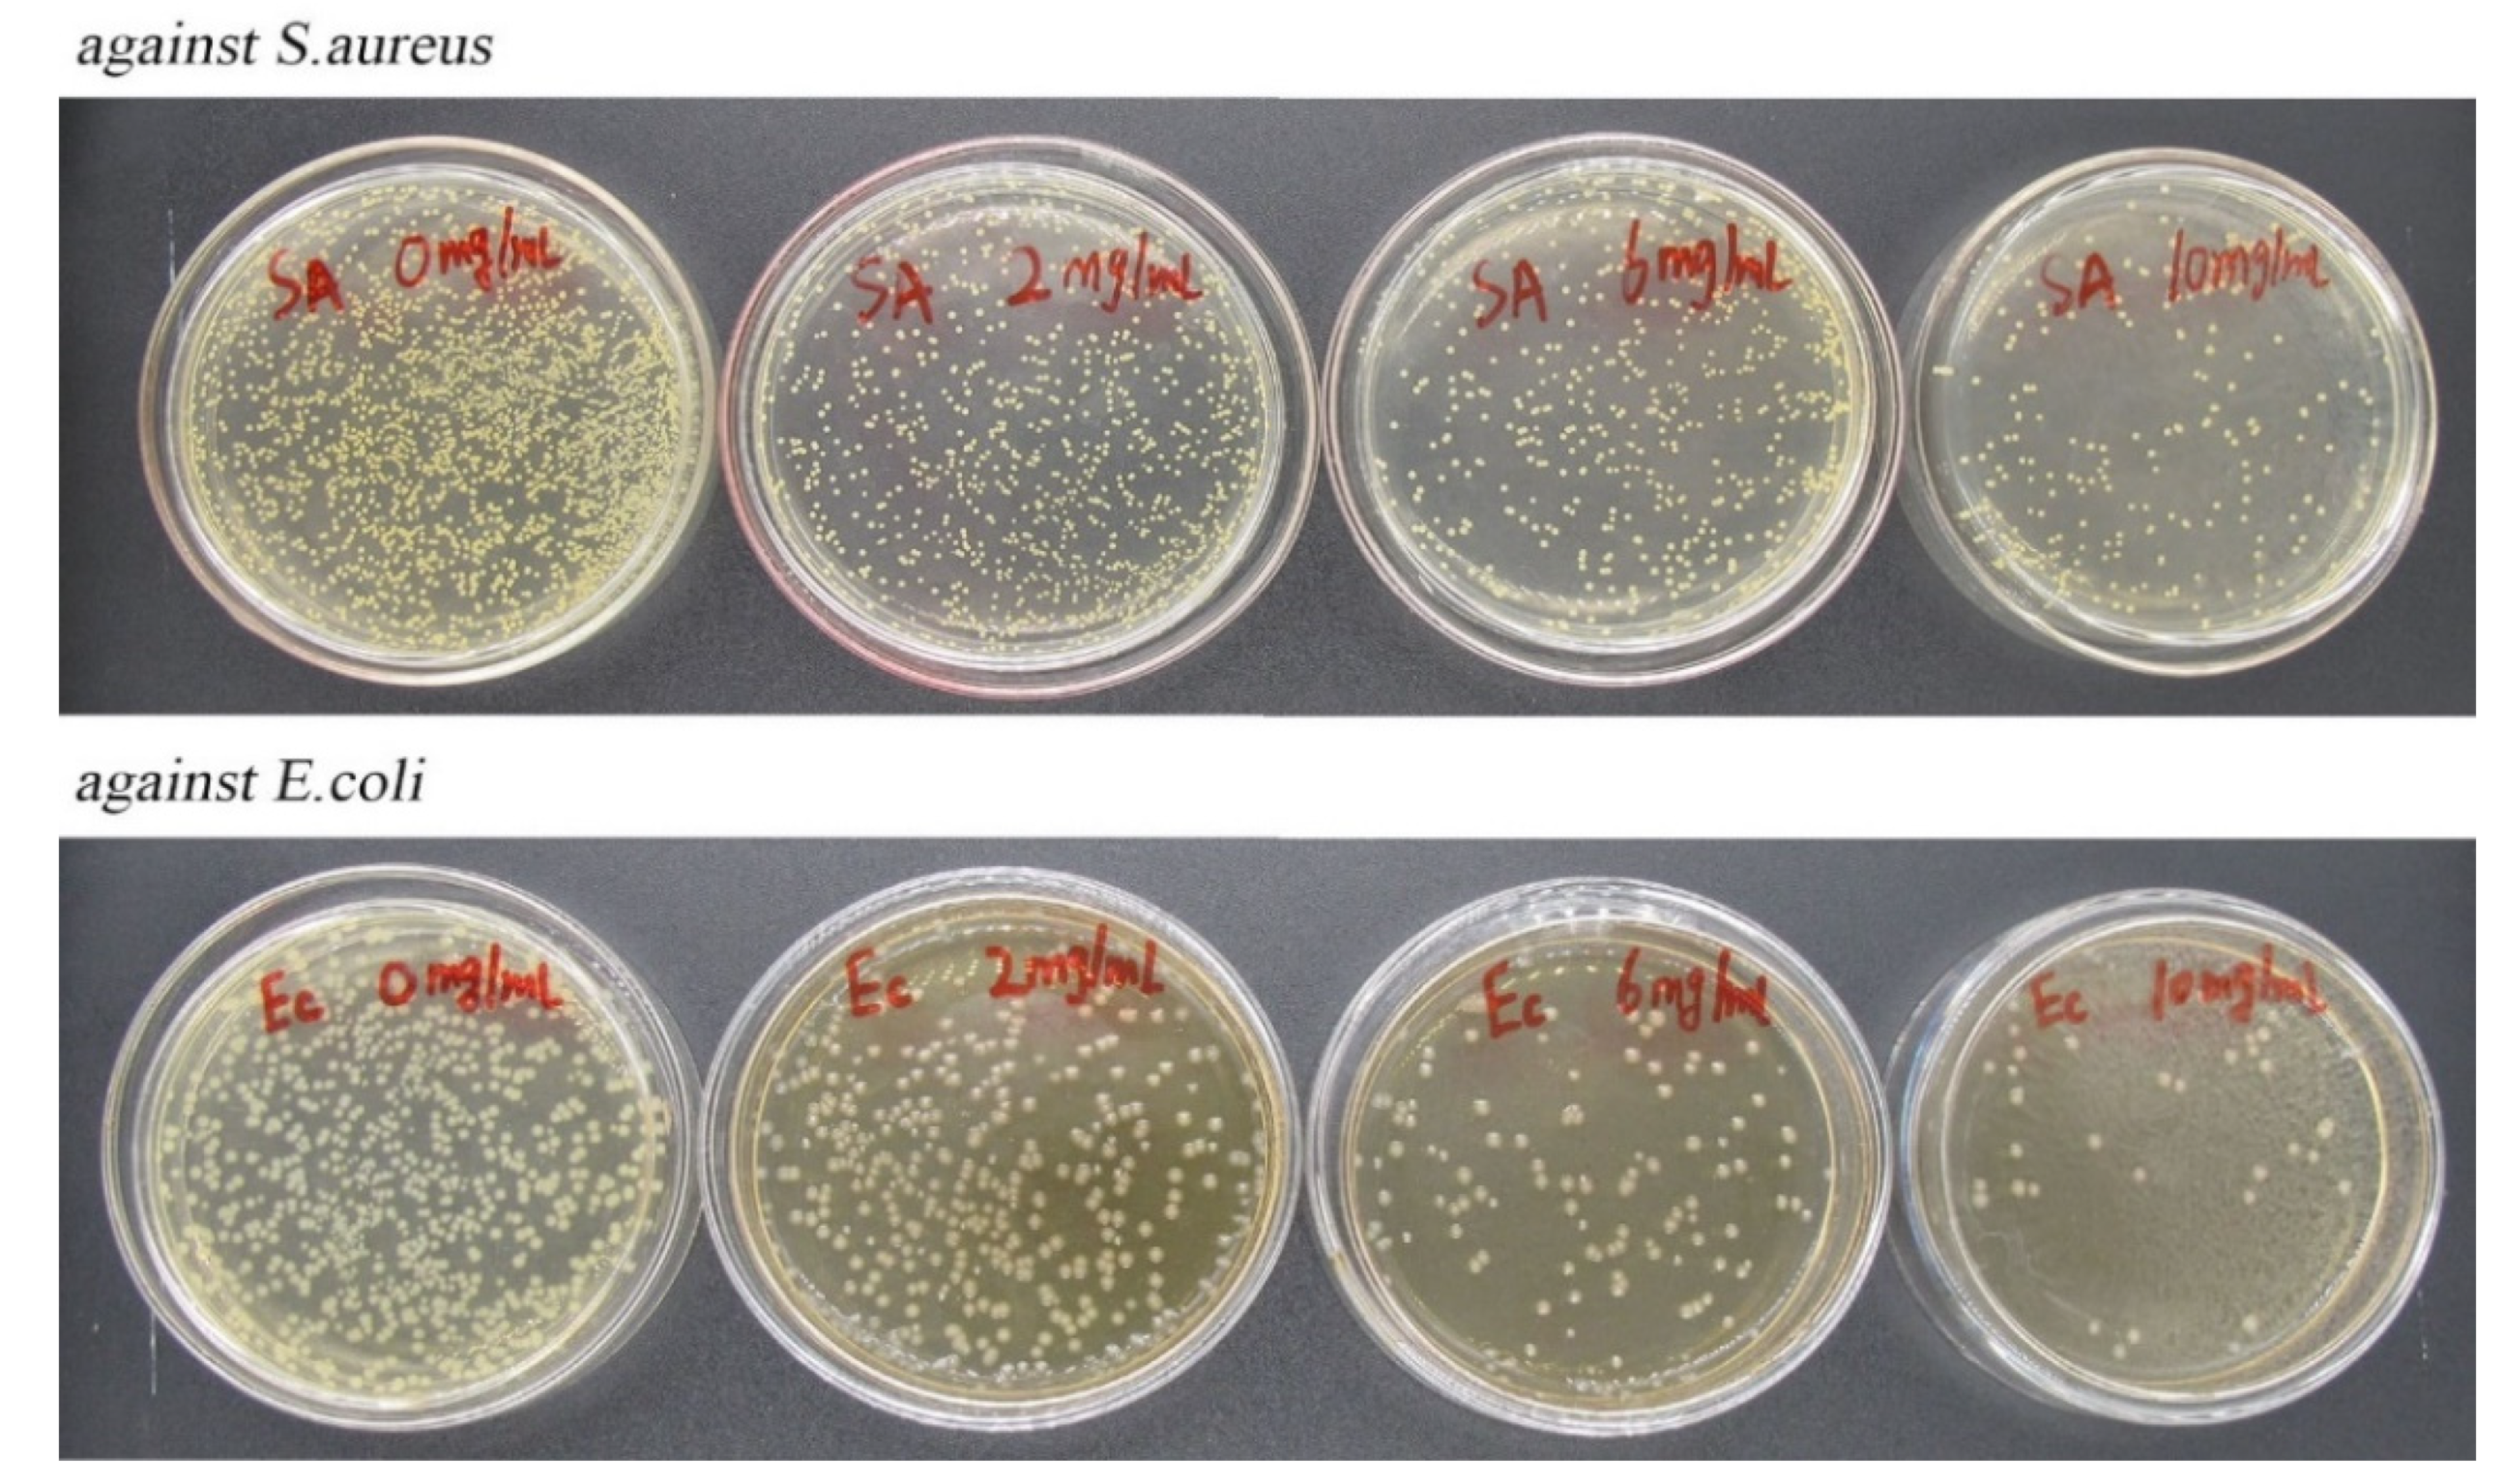

Fabrication, Characterization, and Antimicrobial Activity of Carvacrol-Loaded Zein Nanoparticles Using the pH-Driven Method
Abstract
:1. Introduction
2. Results
2.1. FT–IR Spectroscopy
2.2. EE of CA-Loaded Composite NPs
2.3. Analysis of Particle Size Distribution and Potential
2.4. Analysis of Redispersibility
2.5. Storage Stability of Composite NPs
2.6. Particle Structures Studied with FE–SEM
2.7. Analysis of TG
2.8. Analysis of Antioxidant Capacity
2.9. Analysis of Antimicrobial Activity
2.10. CA-Loaded Composite NPs in Food Storage
3. Discussion
4. Materials and Methods
4.1. Materials
4.2. Preparation of CA-Loaded Composite NPs
4.3. Analysis of Fourier Transform Infrared (FT–IR) Spectroscopy
4.4. Encapsulation Efficiency (EE) of CA-Loaded Composite NPs
4.5. Analysis of Particle Size Distribution and Potential
4.6. Redispersibility Evaluation
4.7. Storage Stability Evaluation
4.8. Analysis of Geometric Morphology
4.9. Thermal Gravimetric Analysis (TGA)
4.10. Antioxidant Activity Evaluation
4.11. Antimicrobial Activity Evaluation
4.12. CA-Loaded Composite NPs in Food Storage
5. Conclusions
Author Contributions
Funding
Institutional Review Board Statement
Informed Consent Statement
Data Availability Statement
Acknowledgments
Conflicts of Interest
References
- Merino, N.; Berdejo, D.; Bento, R.; Salman, H.; Lanz, M.; Maggi, F.; Sánchez-Gómez, S.; García-Gonzalo, D.; Pagán, R. Antimicrobial efficacy of Thymbra capitata (L.) Cav. essential oil loaded in self-assembled zein nanoparticles in combination with heat. Ind. Crops Prod. 2019, 133, 98–104. [Google Scholar] [CrossRef]
- Taskeen, N.; Muhammad, I.; Alan, M. Improving carvacrol bioaccessibility using core–shell carrier-systems under simulated gastrointestinal digestion. Food Chem. 2021, 353, 129505. [Google Scholar] [CrossRef]
- Donsì, F.; Ferrari, G. Essential oil nanoemulsions as antimicrobial agents in food. J. Biotechnol. 2016, 233, 106–120. [Google Scholar] [CrossRef] [PubMed]
- Figueroa-Lopez, K.J.; Torres-Giner, S.; Enescu, D.; Cabedo, L.; Cerqueira, M.A.; Pastrana, L.M.; Lagaron, J.M. Electrospun active biopapers of food waste derived poly(3-hydroxybutyrate-co-3-hydroxyvalerate) with short-term and long-term antimicrobial performance. Nanomaterials 2020, 10, 506. [Google Scholar] [CrossRef] [PubMed]
- Prakash, B.; Kujur, A.; Yadav, A.; Kumar, A.; Singh, P.P.; Dubey, N.K. Nanoencapsulation: An efficient technology to boost the antimicrobial potential of plant essential oils in food system. Food Control 2018, 89, 1–11. [Google Scholar] [CrossRef]
- Silva, F.T.D.; Cunha, K.F.D.; Fonseca, L.M.; Antunes, M.D.; Halal, S.L.M.E.; Fiorentin, Â.M.; Zavareze, E.D.R.; Dias, A.R.G. Action of ginger essential oil (Zingiber officinale) encapsulated in proteins ultrafine fibers on the antimicrobial control in situ. Int. J. Biol. Macromol. 2018, 118, 107–115. [Google Scholar] [CrossRef]
- de Carvalho, S.M.; Noronha, C.M.; Floriani, C.L.; Lino, R.C.; Rocha, G.; Bellettini, I.C.; Ogliari, P.J.; Barreto, P.L.M. Optimization of α-tocopherol loaded solid lipid nanoparticles by central composite design. Ind. Crops Prod. 2013, 49, 278–285. [Google Scholar] [CrossRef]
- Felício, I.M.; Souza, R.L.D.; Melo, C.D.O.; Lima, K.Y.O.; Vasconcelos, U.; Moura, R.O.D.; Oliveira, E.E. Development and characterization of a carvacrol nanoemulsion and evaluation of its antimicrobial activity against selected food-related pathogens. Lett. Appl. Microbiol. 2021, 72, 299–306. [Google Scholar] [CrossRef]
- Xu, T.; Gao, C.C.; Yang, Y.L.; Shen, X.C.; Huang, M.G.; Liu, S.W.; Tang, X.Z. Retention and release properties of cinnamon essential oil in antimicrobial films based on chitosan and gum arabic. Food Hydrocoll. 2018, 84, 84–92. [Google Scholar] [CrossRef]
- Feng, S.M.; Sun, Y.X.; Wang, D.; Sun, P.L.; Shao, P. Effect of adjusting pH and chondroitin sulfate on the formation of curcumin-zein nanoparticles: Synthesis, characterization and morphology. Carbohyd. Polym. 2020, 250, 116970. [Google Scholar] [CrossRef]
- Dai, L.; Wei, Y.; Sun, C.X.; Mao, L.; McClements, D.J.; Gao, Y.X. Development of protein-polysaccharide-surfactant ternary complex particles as delivery vehicles for curcumin. Food Hydrocoll. 2018, 85, 75–85. [Google Scholar] [CrossRef]
- Sun, C.X.; Gao, Y.X.; Zhong, Q.X. Effects of acidification by glucono-delta-lactone or hydrochloric acid on structures of zein-caseinate nanocomplexes self-assembled during a pH cycle. Food Hydrocoll. 2018, 82, 173–185. [Google Scholar] [CrossRef]
- Shukla, R.; Cheryan, M. Zein: The industrial protein from corn. Ind. Crops Prod. 2001, 13, 171–192. [Google Scholar] [CrossRef]
- Kasaai, M.R. Zein and zein—Based nano-materials for food and nutrition applications: A review. Trends Food Sci. Technol. 2018, 79, 184–197. [Google Scholar] [CrossRef]
- Hu, K.; McClements, D.J. Fabrication of surfactant-stabilized zein nanoparticles: A pH modulated antisolvent precipitation method. Food Res. Int. 2014, 64, 329–335. [Google Scholar] [CrossRef]
- Pan, K.; Zhong, Q. Low energy, organic solvent-free co-assembly of zein and caseinate to prepare stable dispersions. Food Hydrocoll. 2016, 52, 600–606. [Google Scholar] [CrossRef]
- Yuan, Y.K.; Xiao, J.Z.; Zhang, P.Y.; Ma, M.; Wang, D.; Xu, Y. Development of pH-driven zein/tea saponin composite nanoparticles for encapsulation and oral delivery of curcumin. Food Chem. 2021, 364, 130401. [Google Scholar] [CrossRef]
- Luo, Y.C.; Zhang, Y.; Pan, K.; Critzer, F.; Davidson, P.M.; Zhong, Q.X. Self-emulsification of alkaline-dissolved clove bud oil by whey protein, gum arabic, lecithin, and their combinations. J. Agric. Food Chem. 2014, 62, 4417–4424. [Google Scholar] [CrossRef]
- Pan, K.; Luo, Y.C.; Gan, Y.D.; Baek, S.J.; Zhong, Q.X. pH-driven encapsulation of curcumin in self-assembled casein nanoparticles for enhanced dispersibility and bioactivity. Soft Matter 2014, 10, 6820. [Google Scholar] [CrossRef]
- Rodriguez, N.J.; Hu, Q.; Luo, Y. Oxidized Dextran as a Macromolecular Crosslinker Stabilizes the Zein/Caseinate Nanocomplex for the Potential Oral Delivery of Curcumin. Molecules 2019, 24, 4061. [Google Scholar] [CrossRef]
- Chang, C.; Wang, T.R.; Hu, Q.B.; Yang, C. Zein/caseinate/pectin complex nanoparticles: Formation and characterization. Int. J. Biol. Macromol. 2017, 104, 117–124. [Google Scholar] [CrossRef]
- Veneranda, M.; Hu, Q.; Wang, T.; Luo, Y.; Castro, K.; Madariaga, J.M. Formation and characterization of zein-caseinate-pectin complex nanoparticles for encapsulation of eugenol. LWT 2018, 89, 596–603. [Google Scholar] [CrossRef]
- Wang, L.; Xue, J.; Zhang, Y. Preparation and characterization of curcumin loaded caseinate/zein nanocomposite film using pH-driven method. Ind. Crops Prod. 2019, 130, 71–80. [Google Scholar] [CrossRef]
- Liu, Y.X.; Liang, Q.F.; Liu, X.Q.; Raza, H.; Ma, H.L.; Ren, X.F. Treatment with ultrasound improves the encapsulation efficiency of resveratrol in zein-gum arabic complex coacervates. Food Sci. Technol. 2022, 153, 112331. [Google Scholar] [CrossRef]
- Luis, A.I.S.; Campos, E.V.R.; de Oliveira, J.L.; Guilger-Casagrande, M.; de Lima, R.; Castanha, R.F.; de Castro, V.L.S.S.; Fraceto, L.F. Zein nanoparticles impregnated with eugenol and garlic essential oils for treating fish pathogens. ACS Omega 2020, 5, 15557–15566. [Google Scholar] [CrossRef]
- Patel, A.R.; Bouwens, E.C.M.; Velikov, K.P. Sodium Caseinate Stabilized Zein Colloidal Particles. J. Agric. Food Chem. 2010, 58, 12497–12503. [Google Scholar] [CrossRef]
- Rodríguez-Félix, F.; Del-Toro-Sánchez, C.L.; Tapia-Hernández, J.A. A new design for obtaining of white zein micro- and nanoparticles powder: Antisolvent-dialysis method. Food Sci. Biotechnol. 2020, 29, 619–629. [Google Scholar] [CrossRef] [PubMed]
- Mocanu, A.M.; Moldoveanu, C.; Odochian, L.; Paius, C.M.; Apostolescu, N.; Neculau, R. Study on the thermal behavior of casein under nitrogen and air atmosphere by means of the TG-FTIR technique. Thermochim. Acta 2012, 546, 120–126. [Google Scholar] [CrossRef]
- Bilenler, T.; Gokbulut, I.; Sislioglu, K.; Karabulut, I. Antioxidant and antimicrobial properties of thyme essential oil encapsulated in zein particles. Flavour Frag. J. 2015, 30, 392–398. [Google Scholar] [CrossRef]
- Burt, S. Essential oils: Their antibacterial properties and potential applications in foods—A review. Int. J. Food Microbiol. 2004, 94, 223–253. [Google Scholar] [CrossRef]
- Rebeca, P.; Jorge, M.; Carlos, G.; Eneko, L.; Gemma, Q.; Ivan, P.; Juan, I. Increased oral bioavailability of resveratrol by its encapsulation in casein nanoparticles. Int. J. Mol. Sci. 2018, 19, 2816. [Google Scholar] [CrossRef]
- Hadidi, M.; Pouramin, S.; Adinepour, F.; Haghani, S.; Jafari, S.M. Chitosan nanoparticles loaded with clove essential oil: Characterization, antioxidant and antibacterial activities. Carbohyd. Polym. 2020, 236, 116075. [Google Scholar] [CrossRef] [PubMed]
- Yildirim, O.C.; Arslan, M.E.; Oner, S.; Cacciatore, I.; Stefano, A.D.; Mardinoglu, A.; Turkez, H. Boron nitride nanoparticles loaded with a boron-based hybrid as a promising drug carrier system for alzheimer’s disease treatment. Int. J. Mol. Sci. 2022, 23, 8249. [Google Scholar] [CrossRef] [PubMed]
- Zheng, H.; Wang, J.; Zhang, Y.; Xv, Q.; Zeng, Q.; Wang, J. Preparation and characterization of carvacrol-loaded caseinate/zein-composite nanoparticles using the anti-solvent precipitation method. Nanomaterials 2022, 12, 2189. [Google Scholar] [CrossRef]
- Wang, L.; Zhang, Y. Eugenol nanoemulsion stabilized with zein and sodium caseinate by self-assembly. J. Agric. Food Chem. 2017, 65, 2990–2998. [Google Scholar] [CrossRef]
- Hamelian, M.; Varmira, K.; Veisi, H. Green synthesis and characterizations of gold nanoparticles using thyme and survey cytotoxic effect, antibacterial and antioxidant potential. J. Photochem. Photobiol. B Biol. 2018, 184, 71–79. [Google Scholar] [CrossRef]

| Sample | 0 d | 15 d | ||
|---|---|---|---|---|
| Potential (mV) | PDI | Potential (mV) | PDI | |
| 4:1 | −32.7 ± 0.404 | 0.176 ± 0.012 | −28.87 ± 1.159 | 0.125 ± 0.0230 |
| 2:1 | −30.9 ± 0.529 | 0.155 ± 0.005 | −29.78 ± 1.210 | 0.139 ± 0.0093 |
| 1:1 | −30.3 ± 0.814 | 0.195 ± 0.007 | −31.90 ± 2.615 | 0.172 ± 0.0027 |
| 1:2 | −29.4 ± 1.069 | 0.358 ± 0.004 | −37.27 ± 2.250 | 0.289 ± 0.0197 |
Publisher’s Note: MDPI stays neutral with regard to jurisdictional claims in published maps and institutional affiliations. |
© 2022 by the authors. Licensee MDPI, Basel, Switzerland. This article is an open access article distributed under the terms and conditions of the Creative Commons Attribution (CC BY) license (https://creativecommons.org/licenses/by/4.0/).
Share and Cite
Zheng, H.; Wang, J.; You, F.; Zhou, M.; Shi, S. Fabrication, Characterization, and Antimicrobial Activity of Carvacrol-Loaded Zein Nanoparticles Using the pH-Driven Method. Int. J. Mol. Sci. 2022, 23, 9227. https://doi.org/10.3390/ijms23169227
Zheng H, Wang J, You F, Zhou M, Shi S. Fabrication, Characterization, and Antimicrobial Activity of Carvacrol-Loaded Zein Nanoparticles Using the pH-Driven Method. International Journal of Molecular Sciences. 2022; 23(16):9227. https://doi.org/10.3390/ijms23169227
Chicago/Turabian StyleZheng, Huaming, Jiangli Wang, Feng You, Mingyu Zhou, and Shengwei Shi. 2022. "Fabrication, Characterization, and Antimicrobial Activity of Carvacrol-Loaded Zein Nanoparticles Using the pH-Driven Method" International Journal of Molecular Sciences 23, no. 16: 9227. https://doi.org/10.3390/ijms23169227
APA StyleZheng, H., Wang, J., You, F., Zhou, M., & Shi, S. (2022). Fabrication, Characterization, and Antimicrobial Activity of Carvacrol-Loaded Zein Nanoparticles Using the pH-Driven Method. International Journal of Molecular Sciences, 23(16), 9227. https://doi.org/10.3390/ijms23169227
